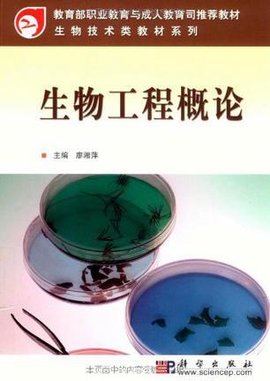
生物工程概论

西安交大 软件工程概论 视频教程 共54讲.avi_w
400x300 - 22KB - JPEG

土木工程行业执业资格考试概论 - 编辑推荐,内
200x200 - 5KB - JPEG

土木工程概论_土木工程概论[土木工程专业十二
222x300 - 8KB - JPEG

土木工程施工概论
300x300 - 10KB - JPEG

建设工程监理概论(含信息管理)答疑精讲与试题
600x862 - 73KB - JPEG

咨询工程师考试《工程咨询概论》基础班视频下
366x300 - 17KB - JPEG

《人体工程学概论》
212x300 - 12KB - JPEG
生物工程概论
270x381 - 21KB - JPEG

价值工程概论
142x200 - 3KB - JPEG

军运车辆装备试验工程概论模板下载(图片编号
650x309 - 25KB - JPEG

铁道线路工程概论 简介,铁道线路工程概论作者
310x310 - 24KB - JPEG

材料科学与工程概论
210x300 - 8KB - JPEG

林业工程概论
268x268 - 9KB - JPEG

土木工程概论_土木工程概论[土木工程专业十二
220x220 - 7KB - JPEG

交通工程概论 - 基本信息,内容简介,目录 - 金山
309x429 - 22KB - JPEG
在线互动式文档分享平台,在这里,您可以和千万网友分享自己手中的文档,全文阅读其他用户的文档,同时,也
2.按软件的功能进行划分,软件可以划分为 系统软件、支撑软件 和应用软件。3.可行性研究主要集中在以下四
软件工程导论期末考试试题 期末考试 试题 我一定可以sa|2012-12-07|暂无评价|0|0|分享至:× 阅读已
软件工程导论期末考试试题试题,期末考试,期末考试题,期末试题,软件工程
软件工程导论期末考试 ztsx|2011-07-11|暂无评价|0|0|简介|系统设计 共享文档 共享文档是百度文库用户
《软件工程导论》期末考试试题和答案 你狠Nice11|2015-07-06|暂无评价|0|0|共享文档 共享文档是百度
软件工程导论期末考试题 蒲柳的坚强|2011-01-11|暂无评价|0|0|简介|必考啊,一定要看 共享文档 共享
软件工程导论期末考试试题 1027162461|2013-05-18|暂无评价|0|0|共享文档 共享文档是百度文库用户免费
软件工程导论期末考试题 随风而逝_微尘|2012-06-23|暂无评价|0|0|简介|软件工程 共享文档 共享文档是